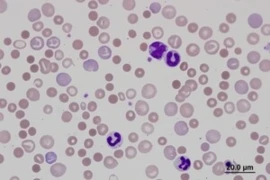

Natalia Otavski
DVM, BVSc, MANZCVS (Avian Medicine and Surgery), MSc (Wildlife Health), BSc (Biomed)

Natalia Otavski
DVM, BVSc, MANZCVS (Avian Medicine and Surgery), MSc (Wildlife Health), BSc (Biomed)
Dr Natalia Otavski completed her Bachelor in Veterinary Science at the University of Sydney in 2015.
She has always had a strong interest in avian and exotic medicine leading her to pursue a career in this field of veterinary science. She has also worked as a veterinarian for companion animals.
In 2021, Natalia was entered as a Member of the Australian and New Zealand College of Veterinary Scientists in the chapter of Avian Medicine and Surgery.
She has also completed a Masters in Wildlife health.
Natalia currently works in a busy Avian and Exotics exclusive clinic in Sydney.
Webinare

Natalie Baudisch
DVM

Natalie Baudisch
DVM
• Mitarbeiterin der Pferdeklinik der FU Berlin – Abteilung Bildgebung/ Orthopädie
• ECVDI Residency in diagnostic imaging, large animal
• FEI Permitted treating veterinarian
• 2021-2025 Ph.D. zum Thema: Engstände der Dornfortsätze, Einfluss chirurgischer Therapiemethoden auf die Biomechanik
• 2023-2024 Internship an der Pferdeklinik FU Berlin
• 2014-2020 Studium der Veterinärmedizin
Webinare

Natalie Bertl
DVM

Natalie Bertl
DVM
- Geboren am 16. Januar 1974 in Luzern, Schweiz
- 1994 – 2000: Studium der Tiermedizin an der LMU München
- 17. Oktober 2000: Approbation als Tierärztin (LMU München)
- Januar 2001- Juli 2004: Doktorandin an der I. Medizinischen Tierklinik der LMU München; Thema der Dissertation: „Bestimmung des „Brain natriuretic Peptide“ (BNP) bei herzkranken Hunden.“
- Juni 2002 – September 2003: wissenschaftliche Mitarbeiterin an der I. Medizinischen Tierklinik der LMU München
- Februar 2004 – September 2004: Wissenschaftliche Mitarbeiterin an der Chirurgischen Tierklinik der LMU München
- 23. Juli 2004: Rigorosum
- Oktober 2004 – Oktober 2007: Beschäftigung als Assistenzärztin an der Tierklinik Haar
- 15. März 2005: Erlangung des Fachtierarzt für Innere Medizin
- Oktober 2007 bis heute: Beschäftigung als Oberärztin für Innere Medizin an der Tierklinik Haar /Anicura Tierklinik Haar
Webinare

Natalie Courtman
DVM, BVSc, MANZCVS, MVS, GCUT, DipACVP

Natalie Courtman
DVM, BVSc, MANZCVS, MVS, GCUT, DipACVP
Natalie graduated from the University of Sydney and spent nine years in small animal practices in Australia and the UK before embarking on her pathology career at the Royal Veterinary College in the UK. She is a Diplomate of the American College of Veterinary Pathologists in clinical pathology, and has a Masters in Veterinary Clinical Studies from Murdoch University and membership of the ANZCVS in Small Animal Medicine and Pathobiology. She has worked in private veterinary laboratories and at the University of Melbourne training DVM students and residents. Her passion is helping vets and vet nurses find and understand the clues that will help them diagnose disease in their patients.
Webinare

Nathalie Dowgray
BVSc, MRCVS, MANZCVS (feline), PGDip IAWEL, PhD

Nathalie Dowgray
BVSc, MRCVS, MANZCVS (feline), PGDip IAWEL, PhD
Nathalie graduated from Massey University, New Zealand in 2002. In 2012 she sat the Membership exams for the Australian and New Zealand College of Veterinary Scientists in Feline Medicine and is a RCVS advanced Practitioner in Feline Medicine. She received a post graduate diploma in international animal welfare ethics and law from Edinburgh University in 2016 and completed a PhD in the ageing of cats at the University of Liverpool in 2021. Nathalie’s areas of interest are all things feline including feline health screening, musculoskeletal disease and age-related disease. Nathalie joined iCatCare as Head of ISFM in August 2020.
Webinare

Nathalie Fouché
DVM, DECEIM

Nathalie Fouché
DVM, DECEIM
Nach meinem Studium der Veterinärmedizin an der Justus-Liebig-Universität Gießen absolvierte ich ein einjähriges Internship am Cotts Equine Hospital in Wales. Anschließend kam ich für meine Doktorarbeit in die Schweiz nach Zürich. Seit 2012 arbeite ich am Schweizerischen Institut für Pferdemedizin (ISME), Pferdeklinik der Vetsuisse-Fakultät der Universität Bern. Dort absolvierte ich das Internship sowie die Residency des European College of Equine Internal Medicine (ECEIM) und bin heute als Oberärztin in der Abteilung für Innere Medizin der Pferdeklinik tätig. Mein fachlicher Schwerpunkt liegt auf endokrinologischen Erkrankungen des Pferdes.
Webinare

Nick Cave
BVSc, MVSc, PhD, MANZCVS, DipACVN

Nick Cave
BVSc, MVSc, PhD, MANZCVS, DipACVN
Nick Cave graduated from Massey University (NZ) in 1990 with a BVSc, and worked in general practice for 6 years until 1997, when he returned to Massey for a residency in small animal internal medicine, and attained membership in the Australasian College of Veterinary Scientists by examination, and graduated with a Masters in Veterinary Science in 2000. In 2004 he moved to the University of California, Davis, where he attained a PhD in nutrition and immunology. At the same time, he completed a residency in small animal clinical nutrition, and became a diplomate in the American College of Veterinary Nutrition by examination in 2004. In late 2005, he returned to Massey University to lecture in small animal medicine and nutrition. He is a founding member of the WSAVA Global Nutrition Committee, and a founding board member for the Massey University Centre for Working Dogs. He has served on the editorial board for Veterinary Quarterly, has authored more than 40 peer-reviewed articles, several textbook chapters, and is a frequent commentator in public media.
Webinare

Nicola Lakeman
MSc, BSc(Hons), RVN, CertSAN, CertVNECC, VTS(Nutrition)

Nicola Lakeman
MSc, BSc(Hons), RVN, CertSAN, CertVNECC, VTS(Nutrition)
Nicola works as the Nutrition Manager for IVC Evidensia. Nicola graduated from Hartpury College with an honours degree in Equine Science, and subsequently qualified as a veterinary nurse in 2002. Nicola has written for many veterinary publications and textbooks and is the editor of Aspinall’s Complete Textbook of Veterinary Nursing. Nicola is one of the Consultant Editors for The Veterinary Nurse. Nicola has won the BVNA / Blue Cross award for animal welfare, the SQP Veterinary Nurse of the Year and the SQP Nutritional Advisor of the Year. Nicola has recently gained her Master’s degree in Advanced Veterinary Nursing with Glasgow University.
Webinare

Nicolas Granger
DVM, PhD, Dip.ECVN, FHEA, MRCVS, EBVS

Nicolas Granger
DVM, PhD, Dip.ECVN, FHEA, MRCVS, EBVS
Nicolas received his veterinary degree from the National Veterinary School of Alfort, France, in 2002, and completed there an internship and neurology/neurosurgery residency. He became a Diplomate of the European College of Veterinary Neurology in 2006 before moving to the UK to run the neurology and neurosurgery service at the Queen’s Veterinary School Hospital, University of Cambridge until 2008. He took a research position in neuroscience at the University of Cambridge, obtaining a PhD in neuroscience in 2012.
Nicolas has worked in the South West of the United Kingdom, Bristol, for the past 7 years, initially as Senior Lecturer in neurology for the University of Bristol and more recently as a clinician for Highcroft Referrals CVS. His research is based at the Royal Veterinary College were he is Senior Research Fellow.
His research focuses on treatments for spinal cord injury in dogs, including transplantation of cells for spinal cord regeneration and repair, clinical trials for new therapies, and neuromodulation for incontinence control.
Webinare

Nicole Biermann-Wehmeyer

Nicole Biermann-Wehmeyer
- 1990 - 1994: Jurastudium in Münster
Abschluss Jurastudium; 3 Monate Australien - 1994 - 1996: Referenzdarzeit Langericht Düsseldorf
- 1997- 2005: Angestellte Unternehmensberaterin bei der GUO Ahaus, Berlin
- 2005: Gründung Biermann Unternehmensberatung / Dozentin Social Media, Kommunikation, Marketing, Recht, Compliance
- 2010 bis heute: Inhaberin Bildungsinstitut Wirtschaft
Social Media Managerin / Speaker (Equitana, Tierärztetag, Tierärztekammer, Messen)
Autorin Enke Verlag und WDT-Verlag
Beraterin interne und externe Kommunikation, Praxisnachfolge, Praxisgründung, Compliance-
Förderprogramme bundesweite Listung - 80% und 50%-Förderung
Webinare

Nicole Luckschander-Zeller
DVM, PhD, Dipl. ACVIM & ECVIM-CA

Nicole Luckschander-Zeller
DVM, PhD, Dipl. ACVIM & ECVIM-CA
- 2009-current: Faculty position: Internal Medicine Service, Gastroenterology service, University of Veterinary Medicine, Vienna, Austria
- 2005-2009: Research associate (PhD): Graduate School for Cellular and Biomedical Sciences, University of Bern, Switzerland
- 2005-2009: Clinical internist: Small Animal Hospital Faculty of Veterinary Medicine, University of Bern, Switzerland
- 2001-2004: Residency Small Animal Internal Medicine, Small Animal Hospital, Faculty of Veterinary Medicine, University of Bern, Switzerland & Louisiana State University, LSU, USA
- 1999-2001: Staff veterinarian: Internal Medicine Service, University of Veterinary Medicine, Vienna, Austria
Webinare

Nicole Stein
DVM

Nicole Stein
DVM
Nicole Stein ist Tierärztin mit der Zusatzbezeichnung Verhaltenstherapie und Mitglied der GTVMT.
Sie ist Mitglied im Prüfungsausschuss zur Sachkunde für Hundetrainer nach §11 des Tierschutzgesetzes der Landestierärztekammer Rheinland-Pfalz. Darüber hinaus ist sie TOP Trainerin und Dozentin der Hundetrainerausbildung an der Tierakademie Scheuerhof.
In ihrer Tierschule „Animal-College“ nimmt das Medical Training einen sehr großen Stellenwert ein. Neben Einzel- und Gruppenstunden bietet sie Medical Training auch im Rahmen von Online-Kursen an.
In ihrer Weiterbildungsreihe „Experte für Medical Training“ schult sie erfolgreich Trainer und engagierte Tierbesitzer.
Zudem hält sie Seminare zu verschiedenen Thema aus dem Bereich Tiertraining in Deutschland, Österreich und der Schweiz.
1991-1997 Studium der Veterinärmedizin an der Justus-Liebig-Universität Gießen
1997-2002 Assistenz in verschiedenen Tierarztpraxen
2002-2009 Elternzeit
seit 2009 Weiterbildung im Bereich Verhaltenstherapie
seit 2011 Tätig in eigener Praxis mit dem Schwerpunkt Verhaltentherapie und der Tierschule „Animal-College“
Webinare

Nicolette Hayward
BVM&S, DVR, DipECVDI, MRCVS, RCVS

Nicolette Hayward
BVM&S, DVR, DipECVDI, MRCVS, RCVS
Nic is a 1986 Edinburgh graduate and spent several years in general practice before specialising in diagnostic imaging at Cambridge University. She gained the RCVS Diploma in Radiology in 2003 and the European Diploma in Veterinary Diagnostic Imaging in 2004.
In 2004/5 Nic was Lecturer in Diagnostic Imaging at the University of Zurich, before returning to private referral practice in the UK. She still lectures extensively on continuing professional development courses in the UK and abroad, and has co-authored book chapters and other veterinary radiological publications.
Nic set up Veterinary Diagnostic Imaging Ltd in 2007 and is Director of the company.
Webinare

Niek Beijerink
DVM, PhD, DECVIM

Niek Beijerink
DVM, PhD, DECVIM
Niek Beijerink graduated with a veterinary degree from Utrecht University in The Netherlands. He completed a PhD (canine endocrinology and reproduction) in 2007 and then a residency in Small Animal Cardiology in 2010. He is a Diplomate of the European College of Veterinary Internal Medicine (Cardiology). In 2011 Niek commenced working as a Specialist in Small Animal Cardiology at Sydney University and is responsible for the clinical service and teaching in this area. Some of his active research interests are heart failure therapy, cardiac CT imaging, and genetics of mitral valve disease. In 2018 Niek moved back to The Netherlands, while he continues to hold a part-time position at Sydney University.
Webinare

BSc (Hons), PGDip(CAB), RVN

BSc (Hons), PGDip(CAB), RVN
A crazy cat lady, and extreme study geek, Nikki is a Scottish Registered Veterinary Nurse, working towards becoming a practice-based Clinical Animal Behaviourist. She holds a Post Graduate Diploma from the University of Edinburgh, as well as a NCert in Animal Behaviour, an ISFM Certificate in Feline Nursing, and ISFM Advanced Certificate in Feline Behaviour. She is also Fear Free Elite, and Low Stress Handling Silver Status qualified. After qualifying as a RVN in 2000, her passion for reducing fear, anxiety and stress in dogs and cats at the vets is ten-fold, and something she wishes to share with peers.